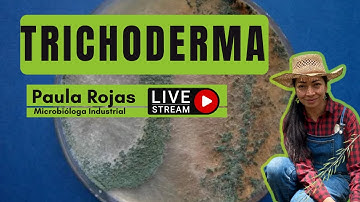
Trichoderma

⬇ DOWNLOAD NOW
Kalau muncul iklan pop-up, tutup lalu klik tombol kembali
Download lagu 🌿 NẤM ĐỐI KHÁNG Trichoderma 🌿 #khoahoccaytrong #tintuc #trangtraihuuco #trangtrai #trichoderma secara gratis hanya untuk keperluan promosi. Dukung artis favorit kamu dengan membeli musik original di iTunes atau platform resmi lainnya.
 Cách Dùng Trichoderma Đúng Chuẩn | Nấm Đối Kháng GEGA Hiệu Quả Tối Đa!
Cách Dùng Trichoderma Đúng Chuẩn | Nấm Đối Kháng GEGA Hiệu Quả Tối Đa!
 Trichoderma Viridae #dragonfruitlover #tropicalfruit #agriculture #dragonfruitplant #farming #plants
Trichoderma Viridae #dragonfruitlover #tropicalfruit #agriculture #dragonfruitplant #farming #plants
 Drenching of tricoderma in plants #farming #agrico #organicfarm
Drenching of tricoderma in plants #farming #agrico #organicfarm
 Trichoderma production - Yeast Molasses Broth
Trichoderma production - Yeast Molasses Broth
 Trichoderma harzianum T22 combats Fusarium oxysporum in tomato
Trichoderma harzianum T22 combats Fusarium oxysporum in tomato
Trichoderma
Trichoderma
 5 UNIQUE Ways of using Trichoderma Bio-fungicide in Garden | How to Multiply Trichoderma Viride?
5 UNIQUE Ways of using Trichoderma Bio-fungicide in Garden | How to Multiply Trichoderma Viride?
 Trichoderma Mold Fungi Timelapse
Trichoderma Mold Fungi Timelapse